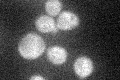
YGL164C
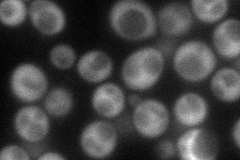
YGL164C
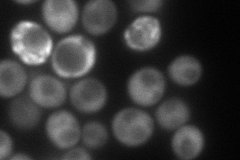
YGL164C
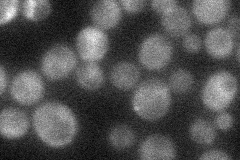
YGL164C
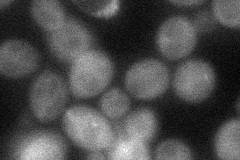
YGL164C
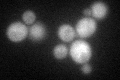
YGL164C
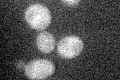
YGL164C
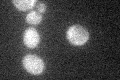
YGL164C

View description
RanGTP-binding protein, inhibits RanGAP1 (Rna1p)-mediated GTP hydrolysis of RanGTP (Gsp1p); shares similarity to proteins in other fungi but not in higher eukaryotes
Localization:
Intensity:
Fold change:
Significance:
-
C’ GFP library in SD
cytosol28.53 -
N' NOP1pr-GFP in SD
cytosol90.7947 -
N' TEF2pr-mCherry in SD
cytosol106.909 -
N' NATIVEpr-GFP in SD
cytosol36.9025 -
N' TEF2pr-VC and Cyto-VN in SD
cytosol42.3058 -
C’ GFP library in SD+DTT
cytosol32.321.13No -
C’ GFP library in SD+H2O2
cytosol33.321.16No -
C’ GFP library in Starvation Media
cytosol29.841.04No -
C’ GFP library on the background of Pup2-DaMP

cytosol -
C’ GFP library on the background of CCT mutant

cytosol29.82951.0452No
